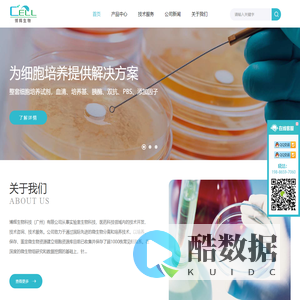
博辉生物科技（广州）有限公司-细胞库

最新
 博辉生物科技(广州)有限公司-细胞库
博辉生物科技(广州)有限公司-细胞库
博辉生物科技(广州)有限公司从事实验室生物科技、医药科技领域内的技术开发、技术咨询、技术服务。公司致力于通过国际先进的微生物分离和培养技术,以培养、保存、鉴定微生物资源建立细胞资源库目前已收集并保存了超1000株常见细胞系。在深度的微生物组研究和数据挖掘的基础上,针对急切和关键的社会市场需求(生物医药、生物农业)提供支持,与合作伙伴携手为客户提供一流的微生物产品及其解决方案。

































